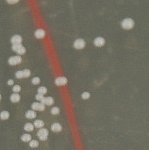
Colony morphology
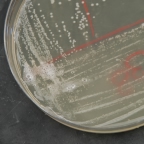
Catalase test

Here are the results for your unknown. Write down the unknown number and then read all the tests. Use the dichotomous key you generated to determine what your isolate is. Finally report this result to your instructor for grading.
You unknown number is 2122 Please do not forget to write this down.
| Reaction | Result |
| Gram Stain | gram-positive cocci |
| Glucose Fermentation Broth |  |
| Lactose Fermentation Broth |  |
| Nitrate Broth |  |
| Motility Medium | |
| Indole Test in Tryptone broth |  |
| Colony Morphology | |
| Catalase Test | |
| Starch Hydrolysis |  |